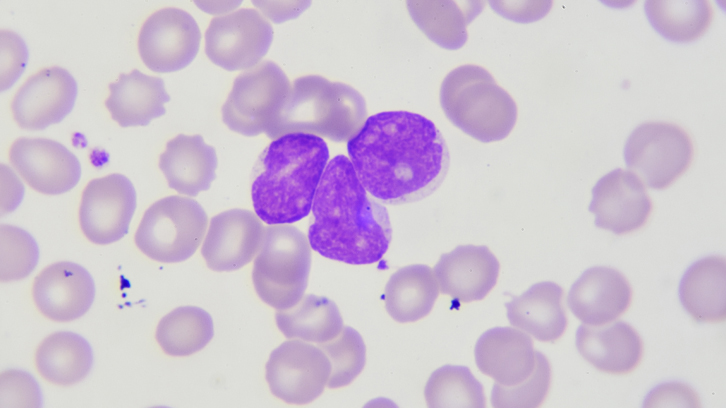
iMPORTANCIA DEL GRADO HISTOLÓGICO EN EL LINFOMA

Les TIC com a factor d’integración de persones majors en democràcia
Aquesta tesi es va proposar conèixer si la formulació de la política pública de la persona adulta major en Cali (Colòmbia) s'ajusta a les orientacions que han fet, des del dret, els organismes...